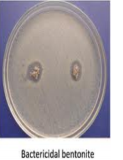

Bilimsel Makale – Bentonitin Bakteri Bağlayabilme Özelliği
Montmorillonitin Bakteri Bağlayabilme Özelliği isimli bilimsel çalışmaya göre, Kalsiyum Bentonitin içinde yüksek oranda bulunan
ve iyileştirici etkisinin başlıca unsuru olan Montmorillonit ile ilgili
olarak aşağıda belirtilen sonuca ulaşmıştır.
bilimsel çalışmaya göre, Kalsiyum Bentonitin içinde yüksek oranda bulunan
ve iyileştirici etkisinin başlıca unsuru olan Montmorillonit ile ilgili
olarak aşağıda belirtilen sonuca ulaşmıştır.
Gümüş
İyonu ile Sentezlenen Bentonitin Antibakteriyel Özelliği
Yakın zamanda yapılan bir diğer çalışmada ise, Gümüş iyonu ile Brazilya’da bulunan bir bentonit türü sentezlenmiş
ve elde edilen maddenin antibakteriyel özelliğe sahip olduğu bulunmuştur.
Gümüş iyonu ile Brazilya’da bulunan bir bentonit türü sentezlenmiş
ve elde edilen maddenin antibakteriyel özelliğe sahip olduğu bulunmuştur.
Bentonitin Ağır Metalleri Giderim Özelliği
Türkiye’de yapılan ve Doğal Bentonitin  Kurşun iyonunu adsorbe etme özelliğini inceleyen bir bilimsel çalışmada,
elde edilen sonuçlar ışığında,
Kurşun iyonunu adsorbe etme özelliğini inceleyen bir bilimsel çalışmada,
elde edilen sonuçlar ışığında,
Doğal bentonitin sulu çözeltiden ağır metallerin giderimi için etkili bir emici olduğu tespit edilmiştir.
Bentonitin Çocuklarda Virüs Tedavisinde Kullanımı
Aşağıda İngilizce özeti verilen diğer bir çalışmada,  Enteritis virüsünün tedavisinde Clostridium Butyricum Tozu ve Montmorillonit
tozunun çocuklar üzerinde düzenli kullanımı gözlemlenmiş ve elde edilen
sonuçlar neticesinde,
Enteritis virüsünün tedavisinde Clostridium Butyricum Tozu ve Montmorillonit
tozunun çocuklar üzerinde düzenli kullanımı gözlemlenmiş ve elde edilen
sonuçlar neticesinde,
Killerin İnsan Sağlığında Etki ve Faydaları
Kill Minerallerinin, İnsan sağlığındaki olumlu etkileri  ve kullanımı üzerine yazılan Literatür makalesinde,
ve kullanımı üzerine yazılan Literatür makalesinde,
Kil minerallerinin, İlaç Formulasyonlarında, Spalarda ve Estetik İlaçlarında
kullanımları tanımlanmış, oral ve yüzeysel kullanımlarda etken madde olarak
terapatik etkileri konuları ele alınmıştır .
Bentonitin İnsan Diyetlerinde Kullanımı
İngilizce özeti aşağıda verilen bir diğer 2005 tarihli çalışmada, Kalsiyum bentonit kilinin insan diyetlerinde, bozulmuş gıdalardan dolayı
oluşan riskleri yok etmede kullanımı ile ilgili kısa vadedeki güvenilirliği
Kliniksel olarak araştırılmış ve çalışmalarda, Kalsiyum Bentonit Kilinin,
istatiksel olarak herhangi bir risk taşımadığı gözlenmiştir.
Kalsiyum bentonit kilinin insan diyetlerinde, bozulmuş gıdalardan dolayı
oluşan riskleri yok etmede kullanımı ile ilgili kısa vadedeki güvenilirliği
Kliniksel olarak araştırılmış ve çalışmalarda, Kalsiyum Bentonit Kilinin,
istatiksel olarak herhangi bir risk taşımadığı gözlenmiştir.
Montmorillonitin Radyoaktif Etkenli Deri Yaralarındaki Koruyucu Etkisi
Montmorillonitin Ultraviyole Radyasyon sonucu  oluşan deri yaralarındaki koruyucu etkilerinin incelendiği yakın tarihli
bir çalışmada, Montmorillonitin, Ultraviyole Radyasyon sonucu oluşan deri
yaralarını korumada iyi bir madde olduğu sonucuna varılmıştır.
oluşan deri yaralarındaki koruyucu etkilerinin incelendiği yakın tarihli
bir çalışmada, Montmorillonitin, Ultraviyole Radyasyon sonucu oluşan deri
yaralarını korumada iyi bir madde olduğu sonucuna varılmıştır.
Montmorillonitin Toksik Gıdalara Karşı Koruyucu Olarak Kullanımı
2012 tarihli bir bilimsel çalışmada aktive edilmiş  Karbon ve Mısır Montmorillonit Kilinin, Deoksinivalenol zehrine karşı
koruyucu olarak kullanımı incelenmiş ve bu çalışmanın sonucunda,
Karbon ve Mısır Montmorillonit Kilinin, Deoksinivalenol zehrine karşı
koruyucu olarak kullanımı incelenmiş ve bu çalışmanın sonucunda,
Montmorillonitin Ağız, El ve Ayak Hastalıklarını Tedavi Etmede Kullanımı
Bir diğer çalışmada, Montmorillonit tozu ve C vitamininin  Pediyatrik el, ayak ve ağız hastalıklarını tedavi etmede kullanılması
konusunda bir araştırma yapılmış ve araştırma sonucunda,
Pediyatrik el, ayak ve ağız hastalıklarını tedavi etmede kullanılması
konusunda bir araştırma yapılmış ve araştırma sonucunda,
Bentonitin Peloterapi Amaçlı Kullanımı
Yapılan bir bilimsel araştırmada,  bentonit ve diğer kil türlerinin Peloterapi amaçlı kullanımı minerelojik,
fiziksel ve kimsayal olarak kıyaslanmış ve araştırmalar sonucunda,
bentonit ve diğer kil türlerinin Peloterapi amaçlı kullanımı minerelojik,
fiziksel ve kimsayal olarak kıyaslanmış ve araştırmalar sonucunda,
Bentonit ve saf killerin Peloterapik amaçlı kullanımda diğer bilindik
kil türlerine kıyasla göze çarpan bir üstünlüğü olduğu gözlemlenmiştir.
Bentonitin, Anti Selülit Tedavisinde Kullanımı
2012 tarihli bir diğer bilimsel çalışmada,  bentonit içeren peloidlerin anti selülit tedavisindeki özellikleri incelenmiş
ve çalışma sonucunda, Bentonit ile geliştirilmiş Peloidlerin anti selülit
tedavilerinde etkili bir metod olduğu tespit edilmiştir.
bentonit içeren peloidlerin anti selülit tedavisindeki özellikleri incelenmiş
ve çalışma sonucunda, Bentonit ile geliştirilmiş Peloidlerin anti selülit
tedavilerinde etkili bir metod olduğu tespit edilmiştir.
Montmorillonit Kili ve YAŞAMIN BAŞLANGICI
Aşağıda ingilizce özeti verilen yakın tarihli bir bilimsel çalışma , Bilim Dünyasında büyük bir yankı uyandırmıştır. Bu çalışmada, montmorillonitin
kilinin RNA ile olan ilişkileri incelenmiş, analizler sonucunda elde edilen
veriler ışığında,
Bilim Dünyasında büyük bir yankı uyandırmıştır. Bu çalışmada, montmorillonitin
kilinin RNA ile olan ilişkileri incelenmiş, analizler sonucunda elde edilen
veriler ışığında,
